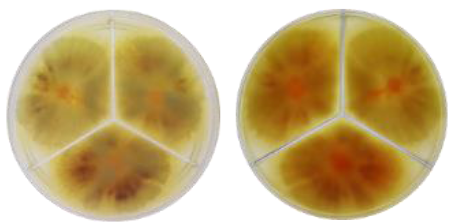
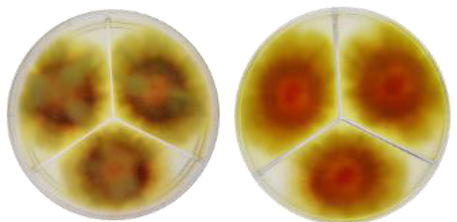
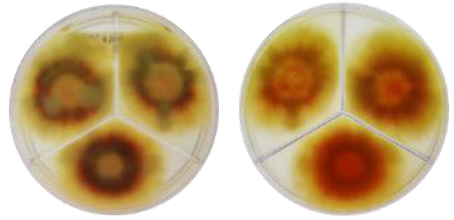
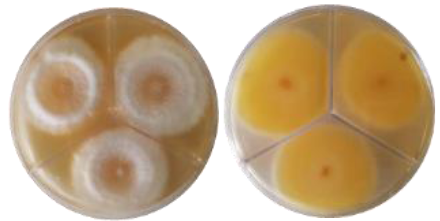
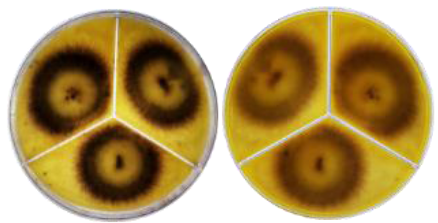
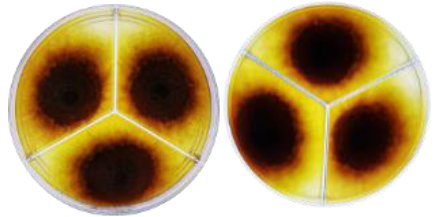
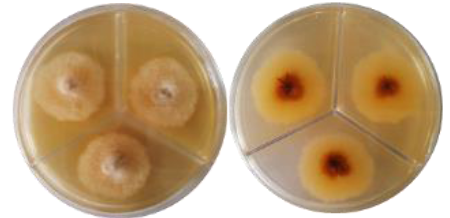
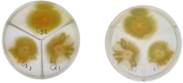
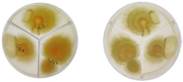
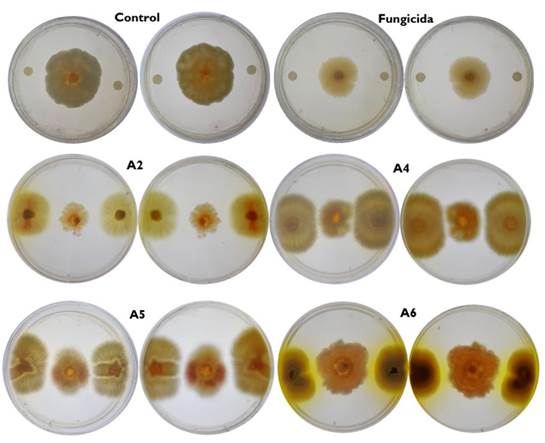

Introducción
Sechium edule (Jacq.) Sw.) es una planta originaria de Mesoamérica que pertenece a la familia de las cucurbitáceas. Produce frutos que se consumen como hortaliza y representan un importante rasgo cultural-culinario en Mesoamérica, en especial para México. El nombre Chayote, proviene del vocablo náhuatl “huizt ayotl” que significa calabaza con espinas que pudo derivar en “Chayotl” y en la actualidad a chayote, lo que ubica el uso de la palabra desde tiempos precolombinos (Cadena-Iñiguez y Arévalo-Galarza 2010). Hoy en día el chayote se cultiva en los cinco continentes, y es apreciable su prosperidad comercial de hortaliza de traspatio a producto no tradicional de exportación. En México su cultivo ocupa 177 759.6 ha con rendimientos a nivel nacional de 5 890.22 t. Los principales estados productores son Guanajuato, Jalisco, Estado de México, Michoacán, Puebla, San Luis Potosí, Tabasco, Nayarit y Veracruz, este último con 2747 ha cultivadas y una producción total de 619 t ha-1 (SIAP 2022).
En S. edule se ha reportado la incidencia de patógenos del género Fusarium en la planta (Aguirre-Medina et al. 2021), en frutos algunos de los patógenos más comunes son Ascohyta phaseolorum, Phom a curcubitacearum, Mycovellosiella cucurbiticola, Colletotrichum sp., Macrophomina phaseoli y Fussarium (Alvarado et al. 1989). En México se han identificado Colletotrichum gloeosporiodes, C. orbiculare, Phytophthora capsici, Geotrichum sp y Fusarium oxysporum (Juárez-Merlín et al. 2007); además Didymella bryoniae, Chaetomium globosum; y F. solani (Romero-Velazquez et al. 2015). Recientemente se reportó por primera vez afectaciones del fruto en postcosecha por F. citri (Montecinos-Pedro et al. 2023), lo cual se relaciona con la contaminación en campo mediante partículas de suelo que llegan al fruto al llover o aplicar riego (Cadena-Iñiguez y Arévalo-Galarza 2010).
Como alternativa para el control de patógenos en postcosecha se tienen los fungicidas sintéticos, pero su uso promueve efectos negativos al medio ambiente, salud del consumidor (Wang et al. 2022) y generan resistencia en los fitopatógenos (Kanini et al. 2013, Rivas-García et al. 2022). Por lo que se están reemplazando a nivel mundial debido al incremento en las exigencias de inocuidad de los alimentos (FAO 2019) por bio fungicidas o controles de origen biológico basados en el uso de microorganismos y/o productos de estos, para contener las enfermedades en planta y fruto (Droby et al. 2009, Suárez-Moreno et al. 2019, Abbas et al. 2020).
Entre los microorganismos utilizados destacan las bacterias, levaduras y actinomicetos, estos últimos son bacterias grampositivas de origen terrestre o marino con potencial de sintetizar una amplia gama de compuestos bioactivos (Imada 2005, Arasu et al. 2013), señalándose de forma general que, el medio ambiente en el que se desarrolle el microorganismo incide sobre el metabolismo microbiano, lo cual ha estimulado que se aíslen microorganismos de hábitat terrestre y marino con el fin de obtener características diversas (Arasu et al. 2013). Sin embargo, desde finales de 1980 el número de nuevos compuestos aislados de microrganismos terrestres ha disminuido de forma constante (Aras et al. 2013), por lo que la inclinación es explorar ambientes inhóspitos como el medio marino (Arasu et al. 2013, Hassan y Shaikh 2017). Proponiéndose como objetivo del presente estudio, evaluar el potencial antagónico de actinomicetos aislados de suelos de manglares en Tuxpan, Veracruz, México frente a aislados de hongos fitopatógenos del fruto de chayote (Sechium edule (Jacq.) Sw.) en postcosecha.
Materiales y métodos
Asilamiento e identificación morfológica de aislados de Fusarium spp.
Se seleccionaron frutos de chayote (S. edule) con lesiones y síntomas de pudrición en la huerta localizada en la localidad de Cuautlapan (18°53'02.8" LN 97°00'59.3" LO). Del área de daño de los frutos de chayote por medio de la técnica punta de hifa (Agrios 2005) se inocularon placas de Petri con medio de cultivo Agar Papa Dextrosa (PDA, Difco 39 g L-1) enriquecido con antibiótico Benzatina Bencilpenicilina (0.1 g L-1), y se incubaron a 28°C por siete días. Para luego resembrar hasta obtener cultivos puros. Los frutos para las pruebas posteriores se colectaron en mercados de la ciudad en madurez comercial, libres de enfermedad y heridas, con tamaños y pesos uniformes.
La identificación macroscópica del fitopatógeno Fusarium spp., se determinó mediante el color, esporulación y tipo de micelio de acuerdo con Summerell et al. (2003). Las características microscópicas como macroconidios, microconidios y clamidosporas de cada hongo se determinaron utilizando el microscopio Velab® con aumento de 40x, a través de las claves taxonómicas de Summerell et al. (2003).
Prueba de patogenicidad
Para la prueba de patogenicidad se siguió la metodología propuesta por Navarta et al. (2014). Los frutos de chayote se lavaron con agua corriente y posteriormente con una dilución de agua destilada y jabón comercial al 10% se enjuagaron. Para luego desinfectar con cloro comercial Cloralex® a concentración del 1%, enjuagándose con agua destilada estéril, dejándolos secar en la campana de flujo laminar Scorpion Scientific® a luz UV por 15 minutos, de forma similar se procedió con la desinfección de las cajas de polipropileno (cámaras húmedas).
Con un bisturí estéril, se realizaron tres heridas por cada chayote en forma de cruz de tres mm por tres mm y dos mm de profundidad, colocando sobre la herida un taquete de dos mm de inóculo del fitopatógeno Fusarium; de concentración 1.106 conidio. mL-1 se ajustó utilizando una cámara de Neubaüer, se utilizó como control frutos de chayote rociados con agua destilada estéril. A los 5 días de almacenamiento, se midió el diámetro de lesión con un vernier digital.
Asilamiento e identificación morfológica de aislados de actinomicetos
Se colectaron 12 muestras de suelo, en cuadrantes de 25x25 cm en manglares ubicados en la comunidad de Tumilco del municipio de Tuxpan, Veracruz al norte del estado (20°55'54.5"LN 97°20'51.3" LO), al cuadrante de suelo en donde se tomó la muestra se le retiró previamente los restos de materia orgánica presentes en la superficie, para luego tomar muestras (1 kg) y depositarlas en bolsas con cierre hermético previamente etiquetadas y transportadas al Laboratorio de Biotecnología y Criobiología Vegetal de la Facultad de Ciencias Químicas de la Universidad Veracruzana, Campus Orizaba.
En el laboratorio, las muestras se homogenizaron para obtener muestras compuestas. De estas se tomaron 25 g que fueron depositados en tubos Falcon® con 50 mL de agua destilada estéril (Daglio et al. 2005). Posteriormente, se tomaron alícuotas que se sembraron en zigzag sobre placas de Petri que contenían PDA (Difco 39 g. L-1) con 5% de agua de mar y Benzatina Bencilpenicilina (0.1 g.L-1); las cuales se incubaron a 37° C durante siete días. A partir de los estriados, las colonias se aislaron mediante la técnica punta de hifa (Agrios 2005) en medio de cultivo PDA se incubaron a 28° C por 7 días hasta obtener cultivos puros.
Para la identificación taxonómica de las cepas de actinomicetos, se evaluaron características como la pigmentación del micelio al reverso y centro de la colonia, forma, tamaño y forma de conidios a los 10 días de incubación. En ese momento, se tomó con un asa estéril una porción de hongo de los cultivos purificados, que se colocó sobre portaobjetos agregando una gota de agua destilada estéril y posteriormente un cubreobjetos para la observación en microscopio a 40X. La identificación macroscópica y microscópica de cada aislado se determinó mediante las claves taxonómicas descritas por Booth (1971), Gerlach y Nirenberg (1982), Nelson et al. (1994).
Antagonismo in vitro de actinomicetos vs. Fusarium spp.
Se colocó un disco de 0.5 cm de cada actinomiceto cultivado en la caja de Petri con PDA (Difco 39 g. L-1) y antibiótico a un centímetro del borde las placas de Petri. En el centro de cada placa se situó un disco de 0.5 cm de Fusarium spp. proveniente de un cultivo de siete días en PDA.
Se establecieron dos grupos experimentales, en el primero, las cajas Petri se inocularon con una cepa de control de Fusarium spp., y el segundo grupo se inoculó con el fitopatógeno más el fungicida Captán al 50%. Se incubaron las placas durante 10 días a 28 °C y se determinó el porcentaje de inhibición del crecimiento radial (PICR, %) del hongo, con la siguiente fórmula:
Donde: R1 es el crecimiento radial del hongo fitopatógeno en la placa control, y R2 es el crecimiento del hongo fitopatógeno en dirección hacia la colonia de actinomicetos (Azadeh et al. 2010). Se realizaron tres replicas (cajas de Petri) por aislamiento de actinomicetos y el experimento se repitió dos veces.
Compuestos orgánicos volátiles (COVs)
Para determinar el efecto de los compuestos volátiles producidos por el antagonista sobre el fitopatógeno, se tomaron cajas de Petri con medio PDA (Difco 39 g L-1), y se utilizaron los conjuntos fondo-fondo, para ello sobre la placa inferior se colocó un disco con el fitopatógeno y en la placa superior un disco con los antagonistas que mejor desempeño tuvieron en la prueba de antagonismo. El conjunto se selló con kleen pack y se incubó a 28 °C por siete días. Como testigo se sembró un disco del patógeno en la base, pero sin el antagonista en la tapa. Se midió el diámetro mayor de las colonias de Fusarium spp., calculando el porcentaje de inhibición del crecimiento radial (PICR) mediante la ecuación declarada anteriormente.
Para la compresión del alcance del efecto antagónico mediante la producción de COVs se consideró la escala de clases de Bell et al. (1982) en sus cinco clases: 1) el antagonista ocupa completamente la superficie del medio de cultivo cubriendo totalmente al patógeno; 2) el antagonista llega a sobrepasar las dos terceras partes de la superficie del medio de cultivo; 3) el antagonista y el patógeno colonizan cada uno aproximadamente la mitad de la superficie del medio y ninguno parece dominar al otro; 4) el patógeno sobrepasa al crecimiento del antagonista colonizando tres cuartas partes de la caja Petri; y 5) el agente fitopatógeno llega a cubrir totalmente la caja Petri.
Diseño experimental y análisis estadístico1 2
La prueba de patogenicidad se desarrolló mediante un diseño experimental completamente al azar, mientras que el resto de las variables se evaluaron mediante un diseño completamente al azar en arreglo factorial con tres repeticiones. Para el análisis estadístico se empleó el software Statistica v 12.0. Se comprobaron los supuestos de homocedasticidad y normalidad según los criterios de Bartlett (Bartlett 1937) y Kolmogorov-Smirnov (Massey 1951), respectivamente. Para la prueba de comparación de medias se consideró el criterio de Tukey a un nivel de confianza del 95%, mientras que para cada uno de los ANOVA se procedió respetando el modelo matemático del diseño experimental aleatorizado y aleatorizado en arreglo factorial, mismos que se declaran a continuación:
Dónde: Yi = variable respuesta; µ = constante común a todas las observaciones; Fui = efecto del i-ésimo Fusarium; ei = error aleatorio ~ N (0, σ2e)
Dónde: Yij = variable respuesta; µ = constante común a todas las observaciones; CACi = efecto de la i-ésima cepa de actinomiceto; CFuj = efecto de la i-ésima cepa Fusarium; CAc x CFuij = efecto de la i-esima cepa de actinomiceto en la j-ésima cepa de Fusarium; eij = error aleatorio ~ N (0, σ2e).
Resultados
Aislamiento y caracterización morfológica de actinomicetos
Se obtuvieron ocho aislamientos de actinomicetos provenientes de manglares de Tuxpan, Veracruz, México; los cuales mostraron diferencias en la morfología de la colonia, tipo de micelio de sustrato. El color del micelio transitó desde blanco, amarillo pálido, naranja pálido, marrón, con textura rugosa, plegada; asimismo las colonias se presentaron de forma irregular, circular y filamentosa, con bordes ondulados, lobulados, enteros y filamentosos, la elevación varió entre plana y convexa (Tabla 1). Las estructuras microscópicas presentaron diferencias con combinaciones entre micro conidios y conidios, micro conidios e hifas, conidios y micro conidios como estructuras independientes (Figura 1).
Tabla 1 Morfología colonial de actinomicetos aislados de suelo de manglar en Tuxpan, Veracruz, México.
Aislamiento y caracterización morfológica de Fusarium spp.
Los aislados de Fussarium (FC1, FC2 y FC3) presentaron diferencias en el color de la colonia, categoría de esporulación y tipo de micelio (Tabla 2). En las estructuras microscópicas, los macroconidios fueron semicurvos, rectos y delgados, con 3 a 5 septos, mientras que los microconidios mostraron forma reniforme y fusiforme, formando de 0 a 1 septo (Figura 2).
Tabla 2 Características morfológicas de colonias de Fusarium spp. aislados de frutos de S. edule (Jacq.) Swartz) obtenidos en la localidad de Cuautlapan, Ixtaczoquitlán, Veracruz, México.
Prueba de patogenicidad
La prueba de patogenicidad de los aislados de Fussarium spp. en frutos de S. edule, tuvo una incidencia del 100% de los hongos patógenos, observándose el inicio de la pudrición al segundo día posterior a la inoculación. Presentando desarrollo radial hasta los siete días de experimentación, momento en el que se tomaron las mediciones de esta variable, en la cual se encontraron diferencias significativas (P ≤ 0.001) entre los aislados, presentando el FC2 mayor crecimiento radial, el FC1 crecimiento radial intermedio y FC3 el crecimiento radial menor (P ≤ 0.001) (Figura 3).
Prueba de antagonismo
La prueba de antagonismo in vitro detectó diferencias significativas (P ≤ 0.001) con respecto a los controles (absoluto y positivo (fungicida)) y entre cada aislado de Actinomiceto spp. con respecto a cada aislado de Fussarium spp. El asilado de actino A1 redujo de forma significativa (P ≤ 0.001) el crecimiento radial del aislado de Fusarium spp. 3 en 38.14% con respecto al control positivo, mientras que el A2 respecto al control positivo redujo el crecimiento micelial de Fussarium spp. 2 en 29.3, y 34.90% en Fussarium spp. 3, respectivamente (Figura 4).
El efecto antagonista se observó nuevamente en el aislado A4 al reducir el crecimiento micelial de los aislamientos de Fussarium spp. 1 y 3 en 56.4 y 61.5%, en orden; y el aislado A5 en los mismos aislamientos de Fussarium spp. redujo el crecimiento micelial en 38.7 y 33.9%, respectivamente; al igual que el aislado A6 redujo el crecimiento micelial de Fussarium spp. 3 en 32.98%, lo cual los ubica con mayor potencial frente a estos patógenos para su uso como controles biológicos.
El crecimiento radial de Fussarium spp. 1 no fue limitado por el efecto antagonista de los aislados A1, A2, y A3, similar sucedió con los aislados A3, A4, A5, A6, A7 y A8 frente a Fussarium spp. 2. Entre los promedios antes mencionados para crecimiento radial al interactuar antagonistas y patógenos no se observaron diferencias significativas (P ≥ 0.05), pero sí de estos respecto a los controles del presente estudio (P ≤ 0.05), de lo que se infiere que existen diferencias en la capacidad antagonista de cada aislado de actinomiceto en el que él patógeno tiene relevancia y define con su capacidad de patogenicidad (Figura 5).
Inhibición mediante compuestos volátiles
En este sentido, en el presente estudio la magnitud de las respuestas en la inhibición del crecimiento radial mediante la producción de compuestos volátiles varió entre 73 y 86.7% pero sin llegar a diferenciarse (P ≥ 0.005) como se observa en la Tabla 3.
Tabla 3 Inhibición del crecimiento radial de Actinomicetos sobre Fusarium spp., mediante la producción de compuestos volátiles (COVs).
| Tratamientos | (Fusarium spp) | ||
|---|---|---|---|
| Aislamiento 1 | Aislamiento 2 | Aislamiento 3 | |
| Crecimiento radial (mm) | |||
| Control | 33.33 ± 2.77a | 36.34 ± 5.71a | 29.74 ± 1.39a |
| Actinomiceto A2 | 11.52 ± 0.90bcd | 10.20+0.07d | 10.25 ± 0.92d |
| Actinomiceto A6 | 9.80 ± 0.85d | 13.08 ± 0.25bcd | 16.10 ± 0.01b |
| Actinomiceto A8 | 11.50 ± 0.42bcd | 15.25 ± 0.42bc | 10.75 ± 0.21cd |
| ±EE | 0.10 | ||
| P | 0.01 | ||
a,b,c,d Al menos con un superíndice en común no difieren significativamente según Tukey para P ≤ 0.05. La significación se alcanzó mediante la transformación √x; ±EE: Error estándar.
Se observó una interacción en el efecto de los actinos con los patógenos para la reducción del crecimiento radial mediante compuestos volátiles. En las combinaciones A6-F1, A2-F2, y A2-F3 el antagonista llegó a sobrepasar las dos terceras partes de la superficie del medio de cultivo, con lo cual lograron reducir entre 25-34% el crecimiento radial mediante la producción de compuestos volátiles, mientras que en los tratamientos A6-F3 y A8-F3, el patógeno sobrepasa al crecimiento del antagonista colonizando tres cuartas partes de la caja Petri diferenciándose significativamente (P ≤ 0.05).
Discusión
Aislamiento y características morfológicas de actinomicetos
Las características morfológicas de los actinomicetos descritos coinciden con las reportadas por Hazarika y Thakur (2020) los que señalaron dentro del género el tipo de pigmentación variada entre las que se encuentran amarillo pálido y blanco-amarillo; también se han reportado colonias de color rojo, violeta, salmón y amarillo (Duarte et al. 2016); naranja pálido y amarillo (García-Ramírez et al. 2023); amarillo pálido y salmón (Montecinos-Pedro et al. 2021). La presencia de pigmentos difusibles no es restrictiva para el género actino si no que se extiende a todos los microorganismos. La intensidad, tono y coloración de los pigmentos difusibles a menudo se relacionan con el tipo de hábitat en los que se puede llegar a encontrar los microorganismos y/o susceptible de variación en función de la composición del medio de cultivo (Parada et al. 2017), generalmente la presencia de estos pigmentos es indicador de la actividad metabólica y pueden utilizarse en la industria alimentaria, textil, farmacéutica, entre otras (Venil et al. 2013, Pérez-Corral et al. 2022), lo que amplía el espectro de uso de los actinos. Mientras que la presencia de estructuras reproductoras (microconidios y macroconidios) pueden o no estar presentes (Murugan et al. 2020), y su morfología variar en todo el Phylum (Hazarika y Thakur 2020). En el presente estudio los hallazgos coincidieron con los reportados por Torres-Rodriguez et al. (2022) en aislados de manglares en ecosistemas de La Paz, Baja California Sur, México.
Asilamiento, caracterización morfológica y patogenicidad de cepas de Fusarium spp.
Con la morfología se confirmó el género del patógeno (Summerell et al. 2003), coincidiendo las descripciones morfológicas a las reportadas por Desvani et al. (2018), y Al-Fadhal et al. (2019). Mientras que la coloración de la colonia coincide con lo observado por Summerell et al. (2003) quienes señalan dentro de los pigmentos difusibles tonos naranja y amarillo claro (Summerell et al. 2003, Okungbowa y Shittu 2012), siendo estas las más comunes entre las diferentes especies de Fusarium (Okungbowa y Shittu 2012). La variabilidad en el crecimiento radial, está vinculado con la patogenicidad y con las características patógenas que caracterizan al género (Leslie y Brett 2013), y las diferencias entre especies que incluyen la velocidad de crecimiento, virulencia, naturaleza del parasitismo y sensibilidad de las especies de plantas a estos hongos patógenos (Urban et al. 2013, Desvani et al. 2018, Murugan et al. 2020).
En este sentido, se ha descrito en frutos de S. edule diferencias sustantivas en la aparición de lesiones en condiciones de campo respecto a condiciones de almacenamiento (Juárez-Merlín et al. 2007). Para la reducción de vida en anaquel coexisten condiciones que favorecen el desarrollo de procesos de infección latentes de Fusarium spp. Por un lado, están las condiciones de almacenamiento y de humedad-temperatura, mientras que, por otro, se encuentran las características de los frutos constituidas por un alto contenido de humedad y tasa de transpiración (Arief et al. 2021); que, en conjunto con el tipo de envase, crean las condiciones ideales para el desarrollo y proliferación de infestaciones por Fussarium spp. que se generaliza durante la manipulación en el proceso de empaque (Cadena-Iñiguez et al. 2006).
Antagonismo in vitro de actinomicetos frente a Fusarium spp.
Las pruebas de antagonismo de actinomicetos frente a Fusarium spp. reportadas por Torres-Rodríguez et al. (2022) en 30 aislamientos de actinos, encontraron que cuatro aislados mostraron halos de inhibición del 70%, lo cual puede estar predispuesto por factores como capacidad de los actinos de producir de manera diversificada metabolitos secundarios del tipo antibiótico, como las enzimas hidrolíticas y actinomicinas con la capacidad de inhibir el crecimiento de patógenos (Chen et al. 2020). También se relacionan otras moléculas mediante las cuáles ejercen su antagonismo como, enzimas del tipo quitinasas (Singh y Gaur 2016), moléculas antimicrobianas (Shan et al. 2018, Rahila et al. 2023), metabolitos secundarios (Walaa y Ahmed 2020), capacidad para la competencia por nutrientes, parasitismo por actividad enzimática (Hazarika et al. 2022) y producción de compuestos volátiles (Di-Francesco et al. 2015, Lyu et al. 2020, Gong et al. 2022). Los mecanismos antes mencionados pudieron mediar en el presente estudio para reducir el crecimiento micelial. Al respecto Meena et al. (2020), reportaron mediante el uso de Streptomyces valores de reducción del crecimiento micelial en Rhizoctonia bataticola del 65.3%, similares a los reportados por Uba et al. (2019), también en Streptomyces se reporta por Boukelloul et al. (2023) la inhibición del crecimiento de Penicillium digitatum, Aspergillus niger y F. solani en un 92, 73 y 72%, respectivamente, ante lo cual, en la similitud de las respuestas obtenidas en el presente estudio, se puede considerar a los aislados de actinos como promisorios para su uso como agentes de control biológico frente Fussarium spp.
Inhibición por COVs
Mediante la escala de Bell et al. (1982) se confirmó la capacidad de los aislados para limitar el desarrollo radial de los patógenos de S. edulek mediante la producción de COVs. Este mecanismo de los actinos se ha reportado por autores como Liu et al. (2013), Di-Francesco et al. (2015), Lyu et al. (2020), frente a patógenos como Aspergillus ochraceus (Yang et al. 2018), Colletotrichum acutatum (Jepsen et al. 2022) y Fusarium spp. (Hazarika et al. 2022, Ruiz-Cisneros et al. 2024). Frente a Fussarium spp. estudios con Streptomyces demostraron la reducción del desarrollo micelial en un 20% (Ayed et al. 2021), proporción inferior a la obtenida en el presente estudio, sin embargo, otros estudios reportan reducciones promovidas por Streptomyces de hasta 77% del crecimiento micelial frente a C. acutatum (Jepsen et al. 2022).
La capacidad de actinos para producir compuestos volátiles radica en la eficacia de producción de compuestos volátiles. Al utilizar a Streptomyces yanglinensis 3-10 como modelo de referencia entre actinobacterias frente a Aspergillus flavus y A. parasiticus, se identificó su capacidad para producir cerca de treinta COVs. Este hallazgo es gran importancia, ya que, aunque se han logrado identificar los COVs, aún no se conoce con precisión si actúan de manera conjunta o individual (Toffano et al. 2017). Desde esta perspectiva, también se debería considerar otros tipos de interacciones entre los COVs, como lo constituye el antagonismo y sinergismo.
Los mecanismos directos por los cuales actúan los COVs sobre los patógenos no se han esclarecido. Pero se sabe que hay varios factores que influyen, entre ellos el tipo de aislamiento, la etapa de crecimiento del organismo, la disponibilidad de nutrientes en el medio, la temperatura y el pH (Di-Francesco et al. 2015). Estos aspectos son importantes al evaluar aislados de diferentes ecosistemas.
Conclusiones
Los aislamientos de actinos provenientes de suelos de manglares actuan como antagónicos directos mediante la producción de compuestos volátiles frente a cepas de Fusarium spp. que afectan al fruto del chayote (Sechium edule (Jacq.) Sw.) en postcosecha. Se obtuvieron ocho aislamientos que, en función de la variabilidad morfológica del micelio y estructuras anexas, podrían tener un amplio rango de aplicaciones biotecnológicas para el desarrollo de soluciones sustentables en la agricultura y otros sectores.